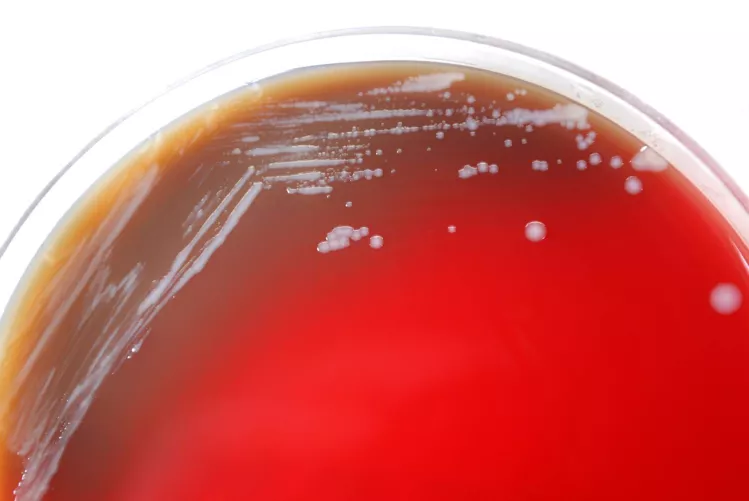
Baktériumtenyészet Petri-csészében

Miközben a világ a madárinfluenza emberre terjedésétől, és az ennek következtében kialakulni képes pusztító járványok kitörésétől fél, a kertek alatt más mikroorganizmusok is próbálnak felzárkózni, magukra vonva mind a szakma, mind az érdeklődő közvélemény figyelmét.
Ezek egyike még csak nem is vírus, hanem egy baktérium. Ennek megfelelően van ellene elsődleges és alternatív antibiotikum terápia. Pánikra tehát semmi ok, de a szaporodó esetek és a lezajlás súlyossága okán a kórokozó indokoltan kerülhet górcső alá, különösen Délkelet-Ázsiában, a szökőár sújtotta területeken, Ausztráliában.
A melioidózisnak (Whitmore-betegség*) nevezett kórképet a Pseudomonas pseudomallei nevű pálcika alakú baktérium okozza. Állóvizekben, pocsolyákban, a nedves talajban él. Ezekből, illetve felszáradásukból a levegő közvetítésével, azaz belélegezve, valamint közvetlen érintkezéssel, sérült vagy látszólag sértetlen (mikrosérült) bőrfelületen keresztül jut az állati és emberi szervezetbe.
A vér útján ez a pálcika eljuthat az agyba, májba, vesékbe, ízületekbe, sőt a szembe is. Leggyakrabban a tüdő érintett, ahol tályogok képződnek. Sok esetben a fertőzés olyan makacsnak bizonyul, hogy a hónapokig tartó antibiotikus terápia sem hoz eredményt. Ekkor tályogfeltárásra, tüdőlebeny-eltávolításra lehet szükség.
A riogatás szándéka nélkül rögzíthetjük a tényt, hogy a betegség letalitása emelkedő tendenciát mutat. Tavaly a Szingapúrban megbetegedettek csaknem 30%-a nem élte túl a fertőzést. Árnyalja a képet, hogy az elhunytak 80%-ának volt valamilyen alapbetegsége (többnyire cukorbetegség vagy magasvérnyomás-betegség), melyek jelentősen gyengíthetik az immunrendszer kórókozóval szembeni ellenállóképességét és az antibiotikumok terápiás hatékonyságát.
Fokozott veszélynek vannak kitéve az intravénás kábítószerélvezők: olyan fatális, a Staphylococcus aureus által okozotthoz hasonló – szívbillenytű-elégtelenséghez vezető – szívbelhártygyulladás jelentkezhet, mely kábítószerrel nem élőknél gyakorlatilag nem fordul elő.
Váli Béla Edgár
orvosiLexikon.hu
(050307)
*Alfred Whitmore (1876-1946), jórészt Indiában tevékenykedett angol sebész